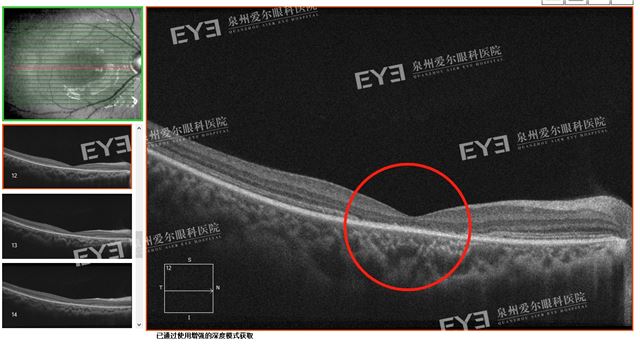
https://img2.danews.cc/upload/images/20241122/3bbe826e82a1b626b60e00e4da4a852d.jpg

(通讯员 苏润钰 黄兰兰)脱口秀综艺节目《喜剧之王》的舞台上一头爆炸头,一副黑墨镜的脱口秀演员黑灯,凭借自己的幽默与才华获得许多人的喜爱。作为视障人群的他,患有罕见病青少年性黄斑变性(即stargardt氏病)也引发关注。近日,泉州爱尔眼科医院眼底病科的副主任医师周瑞武医生也遇到一例类似。
8岁女孩悦悦(化名)在去年视力体检时发现异常,一开始父母不以为意,以为是简单的近视。然而最近一周却发现悦悦左眼视力下降明显,便带她到医院。通过医学验光初步检查发现,悦悦双眼戴镜后的矫正视力也仅为0.2。于是,斜弱视与小儿眼科医生建议悦悦转自眼底科进行更加详细、全面的眼部检查。
没想到通过眼底检查报告,周瑞武医生发现其黄斑“牛眼”状外观,为了明确诊断,进一步完善了荧光血管造影、OCT、电生理等检查,最终周瑞武医生考虑其患有stargardt氏病。据了解,这是一种罕见病目前没有有效的治疗手段,仅能通过干预延缓病情发展。通过详细全面的检查以及多学科会诊,终于找到了悦悦视力下降的元凶。

(眼底检查报告可见黄斑“牛眼”状外观 通讯员供图)

(oct检查报告可见黄斑中心凹神经上皮层外层萎缩 通讯员供图)
连线周瑞武医生科普:stargardt氏病
那么,青少年性黄斑变性(即stargardt氏病)是什么?孩子会什么都看不见吗?泉州爱尔眼科医院周瑞武医生科普道:Stargardt氏病又名少年型黄斑营养不良,是一种常染色体隐性遗传的黄斑萎缩型变性类疾病,常双眼对称发病,男女发病相同,无种族特异性,常在儿童或青少年期发病,也有晚期发病报告。[1]
“这是一种遗传病,它的发病原因和视网膜色素上皮细胞内脂质沉着有关,这类细胞的变性导致黄斑脉络膜和视网膜的萎缩。早期眼底完全正常,但是视力有明显下降,容易被误诊为弱视或者癔症性眼盲,而后黄斑区会逐渐产生灰色颗粒小点,数量越来越多,在短期内会出现视物模糊,颜色感知力下降,甚至视野中心出现暗点等等,发展到晚期黄斑区会呈现出类似于“生锈铜片”的改变。临床表现最常见是,双眼视力对称性进行性下降,大部分视力逐渐下降至0.1,无法矫正,部分下降至指数;伴有畏光,色觉异常,中心暗点和暗适应缓慢。”[2]
(通讯员供图)
周瑞武医生也提醒各位家长,由于该病容易被误诊为弱视,建议在确认孩子是弱视之前,一定要通过检查仔细地排除孩子眼球的器质性病变,并且最好是在一位医生处追踪看诊,不然很容易导致小朋友的关键信息点被遗漏,必要的时候需要进行多学科的会诊。日常可给与叶黄素,玉米黄质,维生素B等营养药物,同时需避免长时间户外日光直射,注意避免强光对黄斑的损伤。
连接关爱:青少年黄斑变性关爱中心
据《冰点周刊》媒体报道《黑灯:向命运投掷包袱》中写道:2019年9月,黑灯和一名病友、一名患者家属,创办了“青少年黄斑变性关爱中心”公众号,发布了第一篇推送文章。公众号的介绍词这样写道:时刻跟踪全球 Stargardt病的研发进展,积极推动相关进程,普及疾病相关知识,扩展医疗资源,汇聚患者,凝聚力量!我们是由一群患者及家属组建的民间团体,我们不能坐以待“盲”,我们希望获得一份清晰的天空!感谢您的支持与理解!
据悉,“青少年黄斑变性关爱中心”公众号主要用来“汇聚患者,共同交流,跟踪医学研究”。同时与各地各类医疗机构建立联系渠道,推动针对这种疾病的科学研究。
[1] Sears A E, Bernstein P S, Cideciyan A V, et al. Towards treatment of stargardt disease:workshop organized and sponsored by the foundation fighting blindness[J]. Translational Vision Science and Technology, 2017, 6(5):6.
[2] 上海市眼病防治中心徐蔚主任医师在个人视频号【徐医生谈眼说睛】发布的【眼疾解惑】合集第34集